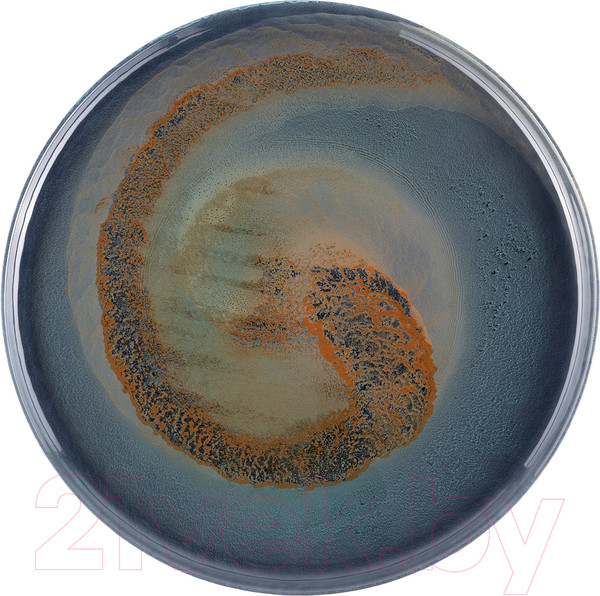

Тарелка столовая обеденная Gipfel Vortex 43212 (синий/зеленый)



+10 бонусов за видеообзор
Материал
стекло
Длина/диаметр
33 см
Ширина
33 см
Высота
2 см

Страна производства: Китай
Производитель: ФДжи Индастри Интернейшнл Ко. ЛТД., 2-й этаж, № 91 Фучуньцзян Роуд , Еко и Тек, Зона развития, Вэньчжоу, Китай / F & J INDUSTRY INTERNATIONAL CO. Ltd., 2nd Floor, No.91 Fuchunjiang Road, Eco. & Tec. Development Zone, Wenzhou, China
Импортер в РБ: Гипфел Бел ООО, 246022, Гомельская обл., Гомель г., пр-т Победы, дом № 8-2
Производители оставляют за собой право изменять внешний вид, характеристики и комплектацию товара, предварительно не уведомляя продавцов и потребителей. Просим вас отнестись с пониманием к данному факту и заранее приносим извинения за возможные неточности в описании и фотографиях товара. Будем благодарны вам за — это поможет сделать наш каталог еще точнее!